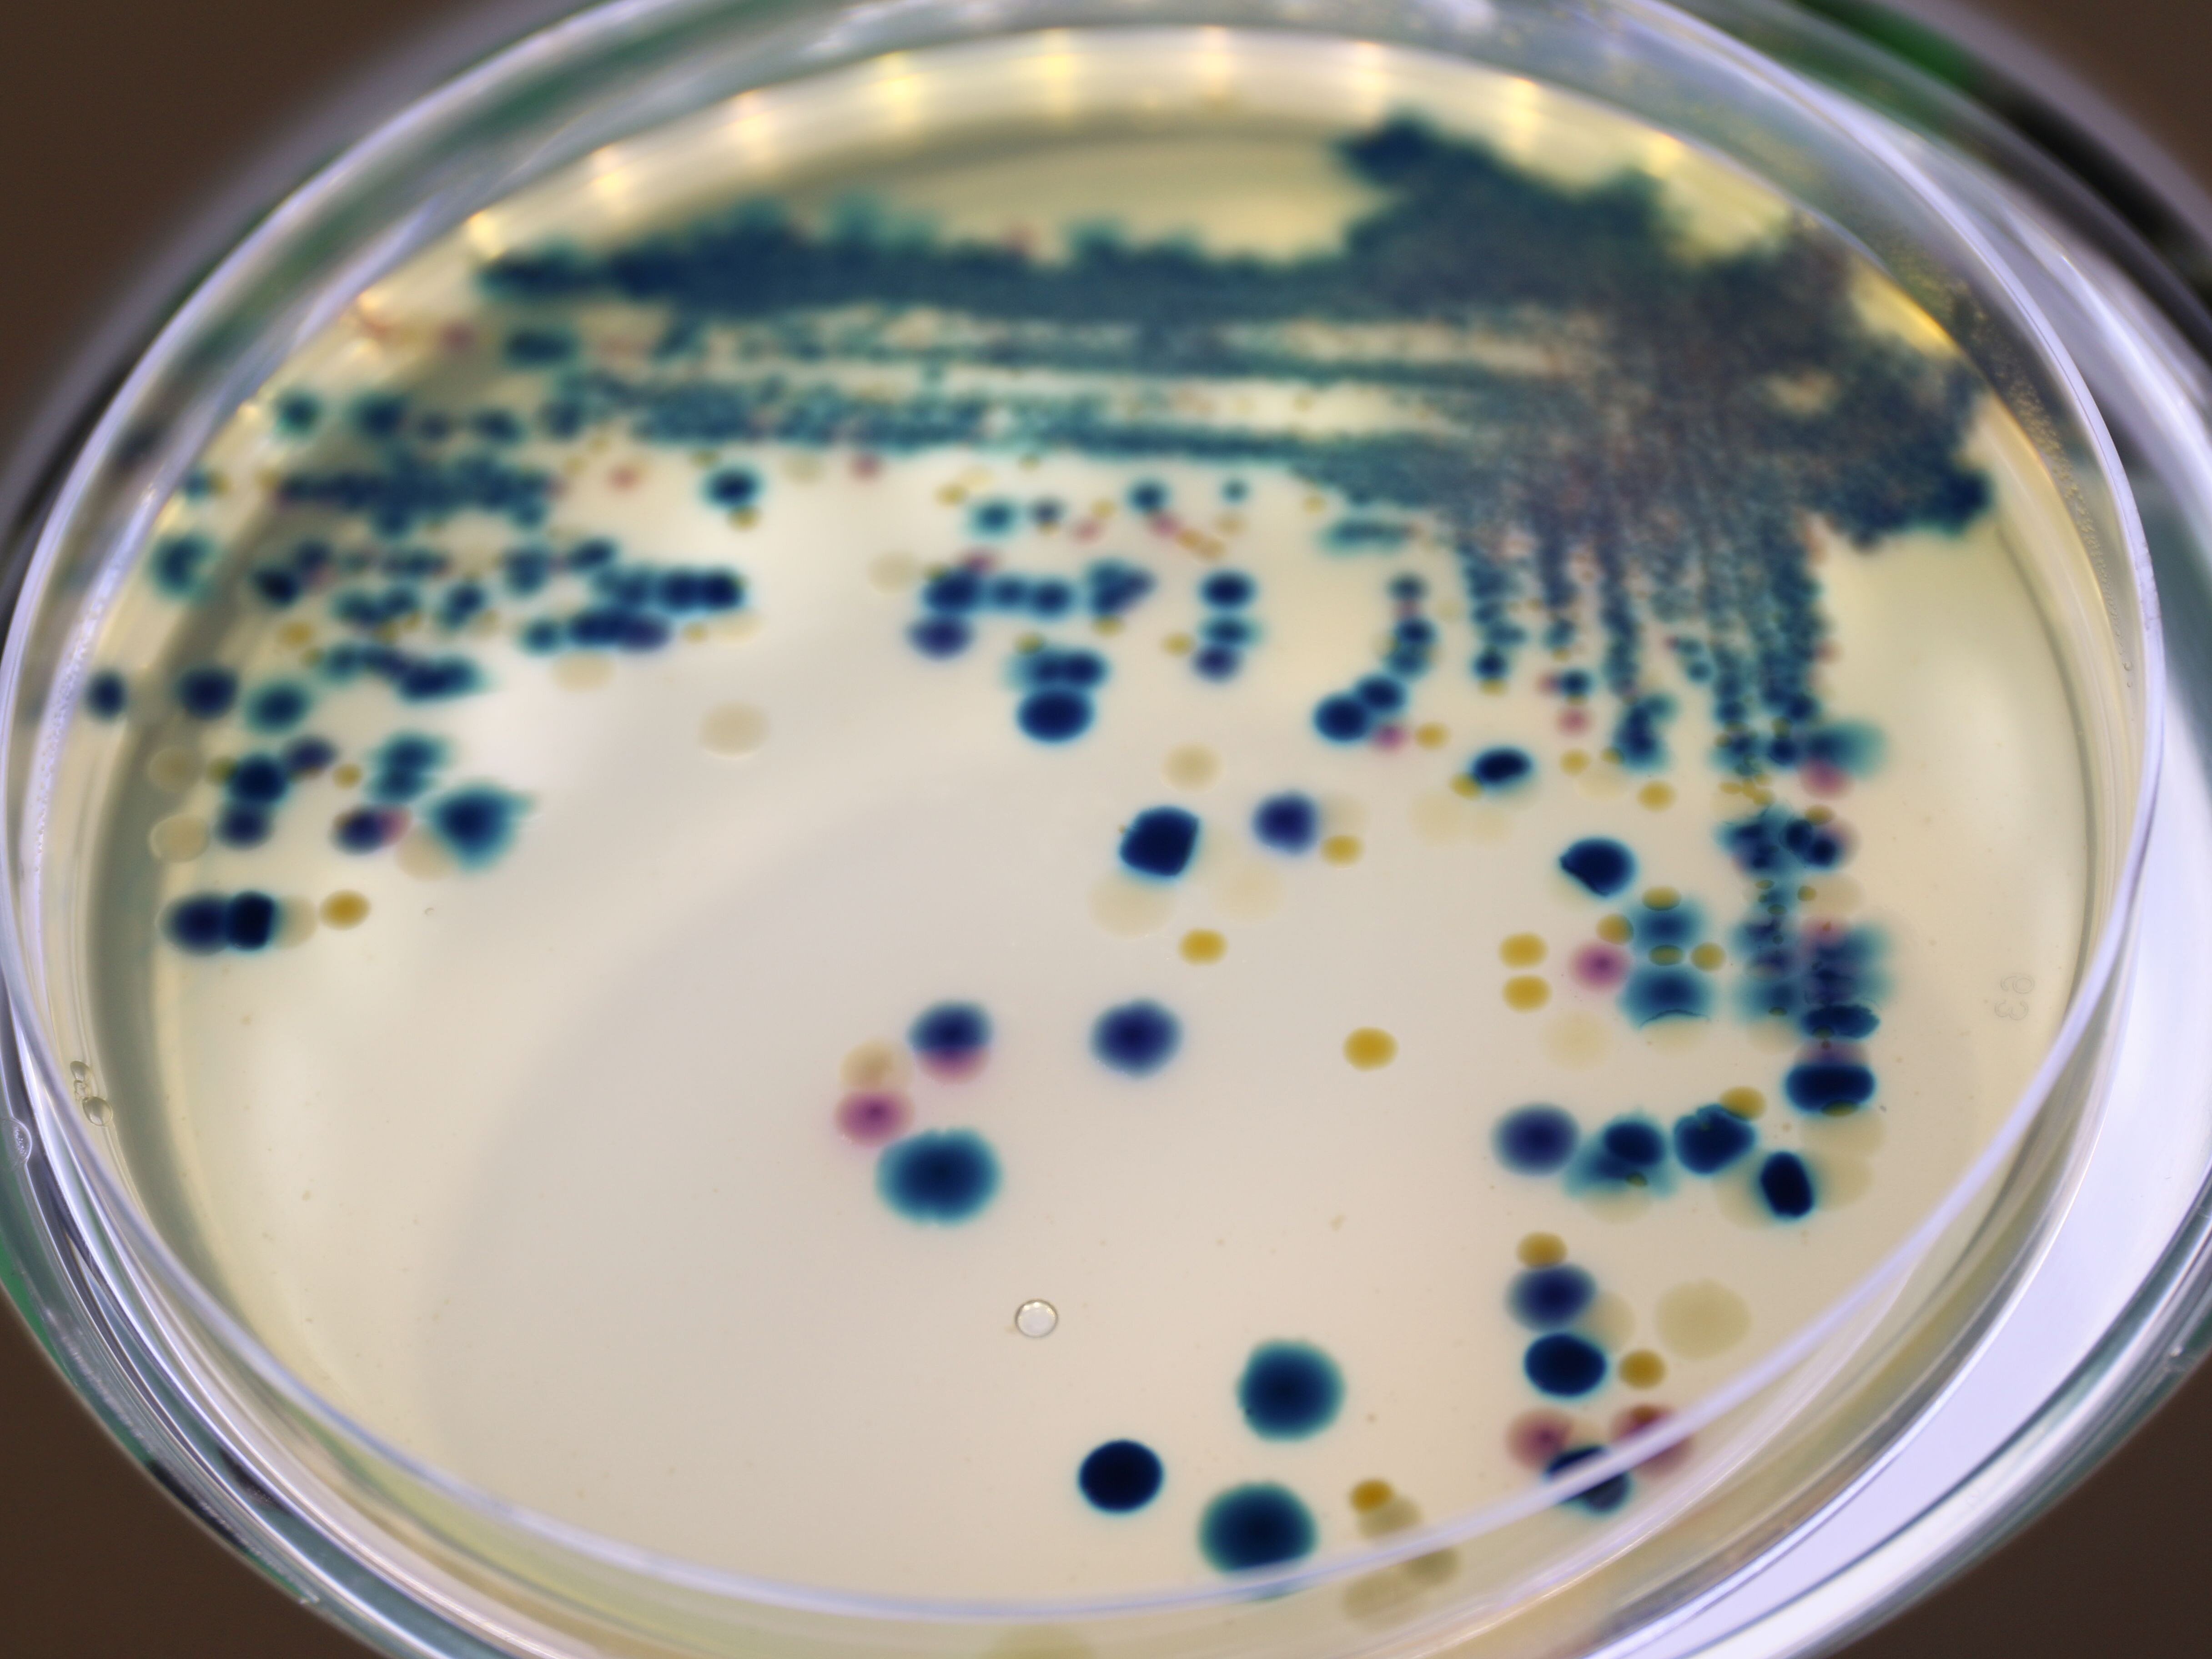
Misch auf Chrom

Epidemiologie und Ökologie antimikrobieller Resistenz

Unsere Forschung

Antimikrobielle Resistenzen (AMR) stellen eine zunehmende Bedrohung für die öffentliche Gesundheit dar. Viele Antibiotika, unverzichtbare Instrumente im Kampf gegen bakterielle Infektionskrankheiten, verlieren ihre Wirksamkeit, da verschiedene und neuartige multiresistente Erreger auf dem Vormarsch sind. AMR entstehen auf natürliche Weise durch Mutationen in den Genen der zu bekämpfenden Bakterien – und können durch horizontalen Transfer von Resistenzgenen zwischen Mikroben übertragen werden. Da Antibiotika routinemäßig und exzessiv zur Bekämpfung bakterieller Infektionen sowohl bei Menschen als auch bei Tieren eingesetzt werden und die Übertragung von Bakterien zwischen diesen Wirten häufig ist, kann eine zunehmende Antibiotikaresistenz beobachtet werden. Darüber hinaus kann sich der Einsatz von Antibiotika in der Veterinär- und Humanmedizin auf Bakterien und AMR in der Umwelt und auf Wildtiere auswirken, z. B. durch die Verschmutzung von Gewässern. Die wechselseitigen Abhängigkeiten zwischen AMR bei Mensch, Tier und Umwelt sowie das rasche Ausbreitungspotenzial von AMR zwischen Bakterienarten machen einen One Health-Ansatz für die Bewältigung dieses dringenden globalen Problems unerlässlich. Wir widmen uns unter anderem der Frage, wie Antibiotikaresistenzen entstehen und sich verbreiten. Dabei umfasst unsere Arbeit nicht nur die Identifizierung und Einordnung klassischer Resistenzen sowie ihre epidemiologische Bewertung, sondern auch die eingehende Untersuchung bakterieller Virulenz- und Fitnessfaktoren, wie etwa die Bildung bakterieller Biofilme, sowie die Etablierung alternativer Therapiestrategien. Mithilfe geno- und phänotypischer Experimente sowie funktioneller und phylogenetischer Genom- und Transkriptomanalysen ist es unser vorrangiges Ziel, erfolgreiche pandemische Krankheitserreger zu analysieren, besser zu verstehen und letztendlich zu bekämpfen.
Unsere Forschung

Antimikrobielle Resistenzen (AMR) stellen eine zunehmende Bedrohung für die öffentliche Gesundheit dar. Viele Antibiotika, unverzichtbare Instrumente im Kampf gegen bakterielle Infektionskrankheiten, verlieren ihre Wirksamkeit, da verschiedene und neuartige multiresistente Erreger auf dem Vormarsch sind. AMR entstehen auf natürliche Weise durch Mutationen in den Genen der zu bekämpfenden Bakterien – und können durch horizontalen Transfer von Resistenzgenen zwischen Mikroben übertragen werden. Da Antibiotika routinemäßig und exzessiv zur Bekämpfung bakterieller Infektionen sowohl bei Menschen als auch bei Tieren eingesetzt werden und die Übertragung von Bakterien zwischen diesen Wirten häufig ist, kann eine zunehmende Antibiotikaresistenz beobachtet werden. Darüber hinaus kann sich der Einsatz von Antibiotika in der Veterinär- und Humanmedizin auf Bakterien und AMR in der Umwelt und auf Wildtiere auswirken, z. B. durch die Verschmutzung von Gewässern. Die wechselseitigen Abhängigkeiten zwischen AMR bei Mensch, Tier und Umwelt sowie das rasche Ausbreitungspotenzial von AMR zwischen Bakterienarten machen einen One Health-Ansatz für die Bewältigung dieses dringenden globalen Problems unerlässlich. Wir widmen uns unter anderem der Frage, wie Antibiotikaresistenzen entstehen und sich verbreiten. Dabei umfasst unsere Arbeit nicht nur die Identifizierung und Einordnung klassischer Resistenzen sowie ihre epidemiologische Bewertung, sondern auch die eingehende Untersuchung bakterieller Virulenz- und Fitnessfaktoren, wie etwa die Bildung bakterieller Biofilme, sowie die Etablierung alternativer Therapiestrategien. Mithilfe geno- und phänotypischer Experimente sowie funktioneller und phylogenetischer Genom- und Transkriptomanalysen ist es unser vorrangiges Ziel, erfolgreiche pandemische Krankheitserreger zu analysieren, besser zu verstehen und letztendlich zu bekämpfen.
Prof. Dr. Katharina Schaufler, PhD
Mein Forschungsinteresse liegt nicht nur in der Aufklärung grundlegender Mechanismen zur Entstehung und Übertragung von Multiresistenzen, sondern auch in der Entwicklung alternativer Strategien zur Bekämpfung von antibiotikaresistenten Pathogenen. In meinem Verantwortungsbereich engagiere ich mich dafür, sicherzustellen, dass auch kommende Generationen weiterhin Zugang zu wirksamen Antibiotika haben.

Im Jahr 2016 erlangte die Veterinärmedizinerin und Mikrobiologin Katharina Schaufler ihre Promotionen (Dr. med. vet. und PhD) zum Thema Antibiotikaresistenzen unter der fachkundigen Betreuung von Herrn Professor Lothar H. Wieler an der Freien Universität Berlin. Ihre akademische Reise im Kontext eines Alexander von Humboldt-Forschungsstipendiums führte sie weiter zur Harvard Medical School in Boston, wo sie wertvolle Erfahrungen unter der Anleitung von Herrn Professor Michael S. Gilmore sammelte. Als Mikrobiologin wurde sie im Jahr 2019 zur Juniorprofessorin für Pharmazeutische Mikrobiologie an der Universität Greifswald ernannt und warb im November 2020 erfolgreich die BMBF-Nachwuchsgruppe "DISPATch_MRGN" ein, welche mit über zwei Millionen Euro dotiert ist. Im Jahr 2021 folgte sie schließlich dem Ruf an die Christian-Albrechts-Universität zu Kiel, wo sie sich der Medizinischen Mikrobiologie widmete. Seit Mitte 2023 ist sie Leiterin der Abteilung ‚Epidemiologie und Ökologie Antimikrobieller Resistenz‘ am Helmholtz-Institut für One Health sowie Professorin an der Universitätsmedizin Greifswald.
Katharina Schaufler zeichnet sich als erfahrene Wissenschaftlerin im Bereich der antimikrobiellen Resistenzen aus und ist ein integraler Bestandteil eines internationalen Expertennetzwerks. Ihre Forschungsaktivitäten sind dem ganzheitlichen One-Health-Ansatz zugeordnet, der mittels modernster bioinformatischer und molekularbiologischer Methoden das übergeordnete Ziel verfolgt, die Gesundheit von Mensch, Tier und Umwelt umfassend zu betrachten. Dabei liegt der Fokus nicht nur auf der Aufklärung grundlegender Mechanismen zur Entstehung und Übertragung von Infektionskrankheiten, sondern auch auf der Entwicklung alternativer Strategien zur Bekämpfung antibiotikaresistenter Pathogene. Zur Verwirklichung ihrer Forschungsvision wirbt sie erfolgreich eine Vielzahl von Drittmittelprojekten ein, gewinnt Preise und publiziert ihre wissenschaftlichen Erkenntnisse in renommierten Fachzeitschriften.
Ausgewählte Publikationen
Schaufler K, Schmidt N, Schwabe M, Heiden SE, Fickenscher H, Who PY, Tien SB, Velavan TP, Song LH, Neumann B, Idelevich EA, Becker K, Krumbholz A, Kocer K, Boutin S, Nurjadi D, Eger E. Rethinking virulence screening in Klebsiella pneumoniae: A case for a standardized Galleria mellonella infection model. The Lancet Microbe. 2026
Müller JU, Eger E, Jana B, Schwabe M, Nurjadi D, Ma Y, Pirolo M, Guardabassi L, Schaufler K. The hidden link between cefiderocol resistance and increased virulence in Klebsiella pneumoniae: insights from a transposon-directed insertion-site sequencing-based investigation. Clin Microbiol Infect. 2026. 32(4):603-609. DOI: 10.1016/j.cmi.2025.12.010
Lübcke P, Heiden SE, Homeier-Bachmann T, Bohnert JA, Schulze C, Eger E, Schwabe M, Guenther S, Schaufler K. Multidrug-resistant high-risk clonal Escherichia coli lineages occur along an antibiotic residue gradient in the Baltic Sea. npj Clean Water. 2024. 7:94. DOI: 10.1038/s41545-024-00394-7
Shaidullina ER*, Schwabe M*, Rohde T, Shapovalova VV, Dyachkova MS, Matsvay AD, Savochkina YA, Shelenkov AA, Mikhaylova YV, Sydow K, Lebreton F, Idelevich EA, Heiden SE, Becker K, Kozlov RS, Shipulin GA, Akimkin VG, Lalk M, Guenther S, Zautner AE, Bohnert JA, Mardanova AM, Bouganim R, Marchaim D, Hoff KJ, Schaufler K*, Edelstein MV*. Genomic analysis of the international high-risk clonal lineage Klebsiella pneumoniae sequence type 395. Genome Med. 2023. 15(1):9. DOI: 10.1186/s13073-023-01159-6
Heiden SE*, Hübner NO*, Bohnert JA, Heidecke CD, Kramer A, Balau V, Gierer W, Schaefer S, Eckmanns T, Gatermann S, Eger E, Guenther S, Becker K, Schaufler K. A Klebsiella pneumoniae ST307 outbreak clone from Germany demonstrates features of extensive drug resistance, hypermucoviscosity, and enhanced iron acquisition. Genome Med. 2020. 12(1):113. DOI: 10.1186/s13073-020-00814-6





